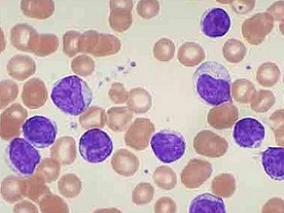
hyper-CVAD联合普纳替尼一线治疗Ph+ALL是否有效？

-
NSAI预处理的ER+MBC患者:依西美坦vs依西美坦+AA
环球医学资讯
2015年12月04日
点击量:460
1小时条评论转移性乳腺癌是晚期乳腺癌治疗的一个难点。2015年10月发表在《Ann Oncol》的一项由美、法、比利时等国科学家进行的研究表明,在NSAI预处理的雌激素受体阳性转移性乳腺癌患者中,与接受依西美坦(E)治疗相比,E添加阿比特龙醋酸盐和泼尼松(AA)不改善PFS。 nbsp; ...
-
高风险胃肠道间质瘤患者使用辅助性伊马替尼的疗效评估
环球医学资讯
2015年12月04日
点击量:270
1小时条评论根据北欧斯堪的纳维亚组XVIII/AIO生存结果,高风险特征的胃肠道间质瘤(GIST)患者给予推荐3年辅助伊马替尼治疗。为了调查该收益是否维持,研究人员进行再一次分析。结果表明,3年的辅助伊马替尼治疗比1年伊马替尼治疗生存期延长。相关报告发表在2015年11月《J Clin ...
-
不能手术切除mCRC患者维持治疗:贝伐单抗是否联合厄…
环球医学资讯
2015年12月04日
点击量:143
1小时条评论2015年11月,发表在《Lancet Oncol.》的一项随机、开放标签、3期研究表明,贝伐单抗联合厄洛替尼维持治疗是不能手术切除的转移性结直肠癌患者贝伐单抗一线诱导治疗后一种新的基于非化疗治疗的维持治疗选择。 背景:抗血管内皮生长因子(VEGF)或抗表皮生长因子受体...
-
急性髓性白血病患者异体造血干细胞移植的备选方案
环球医学资讯
2015年12月04日
点击量:178
1小时条评论2015年11月,发表在《Lancet Oncol》的一项研究表明,在老年急性髓系白血病患者中,白消安+氟达拉滨清髓性预处理方案比白消安+环磷酰胺预处理方案降低移植相关死亡率,但仍保留强效的抗白血病活性,应视为异基因移植患者的标准治疗。 背景:在40岁以上的经历异基因...
-
抗孕激素药物米非司酮治疗不可切除的脑膜瘤是否有效?
环球医学资讯
2015年12月04日
点击量:243
1小时条评论70%的脑膜瘤会表达孕激素受体。先前有II期试验结果表明,口服米非司酮对脑膜瘤可起一定疗效。2015年11月,发表在《J Clin Oncol.》的一项前瞻性、随机、安慰剂对照的III期试验表明,长期给药米非司酮虽然耐受性良好,但对不可切除的脑膜瘤患者并没有影响。 目的:70...
-
美国临床肿瘤学会更新化疗止吐指南
环球医学资讯
2015年12月03日
点击量:527
1小时条评论美国临床肿瘤学会对化疗止吐指南的关键推荐意见进行了更新。2015年11月,发表在《J Clin Oncol》上的一项研究对推荐意见基于的研究进行了回顾。 nbsp; 目的:美国临床肿瘤学会对其止吐指南的关键推荐意见进行了更新。本次更新阐述了口服奈妥吡坦(神经激肽1[NK1]受...
-
MOSAIC研究10年随访结果:结肠癌患者使用FOLFOX方案…
环球医学资讯
2015年12月03日
点击量:1658
1小时条评论MOSAIC研究结果已经显示,奥沙利铂辅助治疗用于II-III期结肠癌切除术后有3年何6年的生存获益。2015年11月,发表在《J Clin Oncol》上的该研究随访10年的结果再次证实,在这些患者中,以草酸铂为基础的辅助化疗的OS获益,随着时间推移和疾病严重程度增加而增加。 nbs...
-
分子异质性影响乳腺癌患者新辅助HER2靶向治疗的效果
环球医学资讯
2015年12月03日
点击量:505
1小时条评论人表皮生长因子(HER2)双靶向治疗能够增加乳腺癌患者新辅助治疗的病理学完全缓解率(PCR)。2015年11月,发表在《J Clin Oncol》上的一项研究显示,对于II-III期HER2阳性乳腺癌患者,HER2双靶向治疗的pCR并未显著高于单靶向治疗,与瘤体内部异质性相关。 nbsp; 目...
-
hyper-CVAD联合普纳替尼一线治疗Ph+ALL是否有效?
环球医学资讯
2015年12月03日
点击量:430
1小时条评论普纳替尼已经被美国和欧盟批准用于治疗慢性粒细胞白血病及费城染色体阳性的急性淋巴细胞白血病的罕见用药。2015年11月,发表在《Lancet Oncol》上的一项研究显示,化疗联合普纳替尼对于初诊费城染色体阳性急性淋巴细胞白血病患者可有效达到早期持续缓解。 nbsp; 背...
-
转移性胰腺癌患者吉西他滨+维莫德吉的疗效评估
环球医学资讯
2015年12月03日
点击量:332
1小时条评论胰腺癌恶性度高,病程短,一般出现症状时已属晚期,并很快发生转移,侵犯邻近脏器。2015年11月发表在《J Clin Oncol.》的一项研究考察了转移性胰腺癌患者吉西他滨+维莫德吉的疗效评估。 nbsp; 目的:Sonic hedgehog(SHH)(一种调节性蛋白,控制着大脑发育相关基...

会员登录

